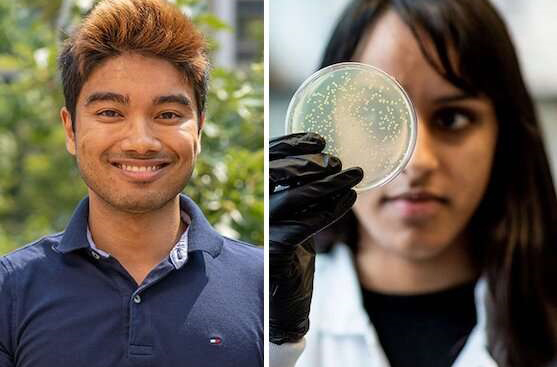

Tìm thấy protein chỉnh sửa gene mới ngoài CRISPR
Trong thập kỷ qua, các nhà khoa học đã sử dụng các hệ CRISPR từ vi khuẩn thành công nghệ chỉnh sửa gene, một hệ có thể lập trình và có tính chính xác cao để biến đổi DNA.
Hai đồng tác giả thứ nhất Han Altae-Tran (Trái) và Soumya Kannan của nghiên cứu.
Giờ đây, các nhà khoa học tại Viện Nghiên cứu não McGovern của MIT và Viện Nghiên cứu Broad của MIT và Harvard đã phát hiện một hệ thống chỉnh sửa DNA có thể lập trình mới, gọi là OMEGAs (Obligate Mobile Element Guided Activity), vốn có thể liên quan một cách tự nhiên đến việc sắp xếp lại các đoạn DNA nhỏ thông qua các bộ gene của vi khuẩn.
Những enzyme cổ có khả năng cắt DNA này được các mảnh nhỏ RNA dẫn đường đến các đích. Dù bắt nguồn từ vi khuẩn, giờ đây các nhà khoa học có thể thiết kế để chúng có thể hoạt động trong tế bào người. Chúng có thể hữu ích trong việc phát triển những liệu pháp chỉnh sửa gene, đặc biệt do có kích thước nhỏ – chỉ bằng khoảng 30% kích thước của enzyme Cas9 thường dùng trong CRISPR – nên chúng dễ dàng đi đến các tế bào hơn những loại enzyme có kích thước lớn khác.
Xuất bản trên tạp chí Science, nghiên cứu cho thấy các enzyme tự nhiên do RNA dẫn đường là một trong những protein phong phú nhất trên Trái đất và nó mở đường tới một lĩnh vực sinh học mới vô cùng rộng lớn, có thể thúc đẩy cuộc cách mạng tiếp theo về công nghệ chỉnh sửa gene.
Người dẫn dắt nghiên cứu này là giáo sư khoa học thần kinh Feng Zhang của MIT và là thành viên của Viện Y khoa Howard Hughes và Viện Broad. Nhóm của Zhang đã xem xét đa dạng tự nhiên để tìm kiếm các hệ thống phân tử mới có thể được lập trình một cách hợp lý. “Chúng tôi hết sức vui mừng khi phát hiện ra các enzyme phổ biến có thể lập trình này, chúng nằm ngay dưới mũi chúng ta suốt một thời gian dài”, ông nói.
Các enzyme có thể lập trình, đặc biệt là những enzyme sử dụng RNA làm kẻ dẫn đường, có thể được điều chỉnh nhanh chóng cho nhiều ứng dụng khác nhau. Ví dụ, các nhà khoa học có thể hướng chúng đến bất kì mục tiêu nào bằng cách tạo ra RNA hướng dẫn của mình. “Thật dễ dàng thay đổi một trình tự gene dẫn đường và thiết lập một mục tiêu mới. Vì vậy, một trong những vấn đề lớn mà chúng tôi quan tâm là liệu các hệ thống tự nhiên khác có sử dụng cùng một dạng cơ chế không”, Soumya Kannan, đồng tác giả bài báo cho biết.
Những gợi ý đầu tiên là các RNA dẫn đường cho protein OMEGA có thể đến từ IscBs, những gene tạo ra protein. IscBs không liên quan đến khả năng miễn dịch CRISPR và không có mối liên hệ với RNA nhưng chúng có vẻ giống các enzyme nhỏ có khả năng cắt DNA. Nhóm nghiên cứu phát hiện ra, mỗi IscBs có một đoạn RNA nhỏ được mã hóa gần đó chỉ đạo các enzyme IscBs cắt các chuỗi DNA cụ thể. Họ đặt tên cho những RNA này là “ωRNAs”.
Thí nghiệm cho thấy hai loại protein nhỏ khác được gọi là IsrBs và TnpBs thuộc một trong những gene phong phú nhất trong vi khuẩn cũng sử dụng ωRNAs như một kẻ hướng dẫn để chỉ đạo việc phân cắt DNA. Ba loại protein IscBs, IsrBs và TnpBs được tìm thấy trong các yếu tố di truyền động gọi là transposons. Mỗi khi các transposon này di chuyển, chúng tạo ra một RNA dẫn đường mới, cho phép enzyme mà chúng mã hóa cắt ở một vị trí khác.
Không rõ vi khuẩn được hưởng lợi như thế nào từ việc sắp xếp lại gene này, hoặc liệu chúng có lợi gì không. Kannan nói rằng transposons thường được coi là những mảnh DNA ích kỷ, chỉ quan tâm đến khả năng di chuyển và bảo tồn của chính nó. Nhưng nếu một vật chủ có thể “kết nạp” các hệ thống này và tái sử dụng chúng theo mục đích khác thì vật chủ đó sẽ có được những khả năng mới, giống như việc các hệ thống CRISPR đem lại khả năng miễn dịch thích ứng.
IscBs và TnpBs dường như là tiền thân của hệ thống CRISPR Cas9 và Cas12. Nhóm nghiên cứu ngờ rằng cũng như IsrBs, nhiều loại enzyme do RNA dẫn đường khác có thể xuất hiện, và họ mong tìm thấy chúng. Kannan cho biết họ rất tò mò về phạm vi chức năng tự nhiên của các enzyme do RNA dẫn đường, và ngờ rằng sự tiến hóa đã tận dụng các enzyme OMEGA như IscBs và TnpBs để giải quyết các vấn đề mà những nhà sinh học hiện đang xử lý. □
Trang Linh dịch
Nguồn: https://www.broadinstitute.org/news/new-programmable-gene-editing-proteins-found-outside-crispr-systems
